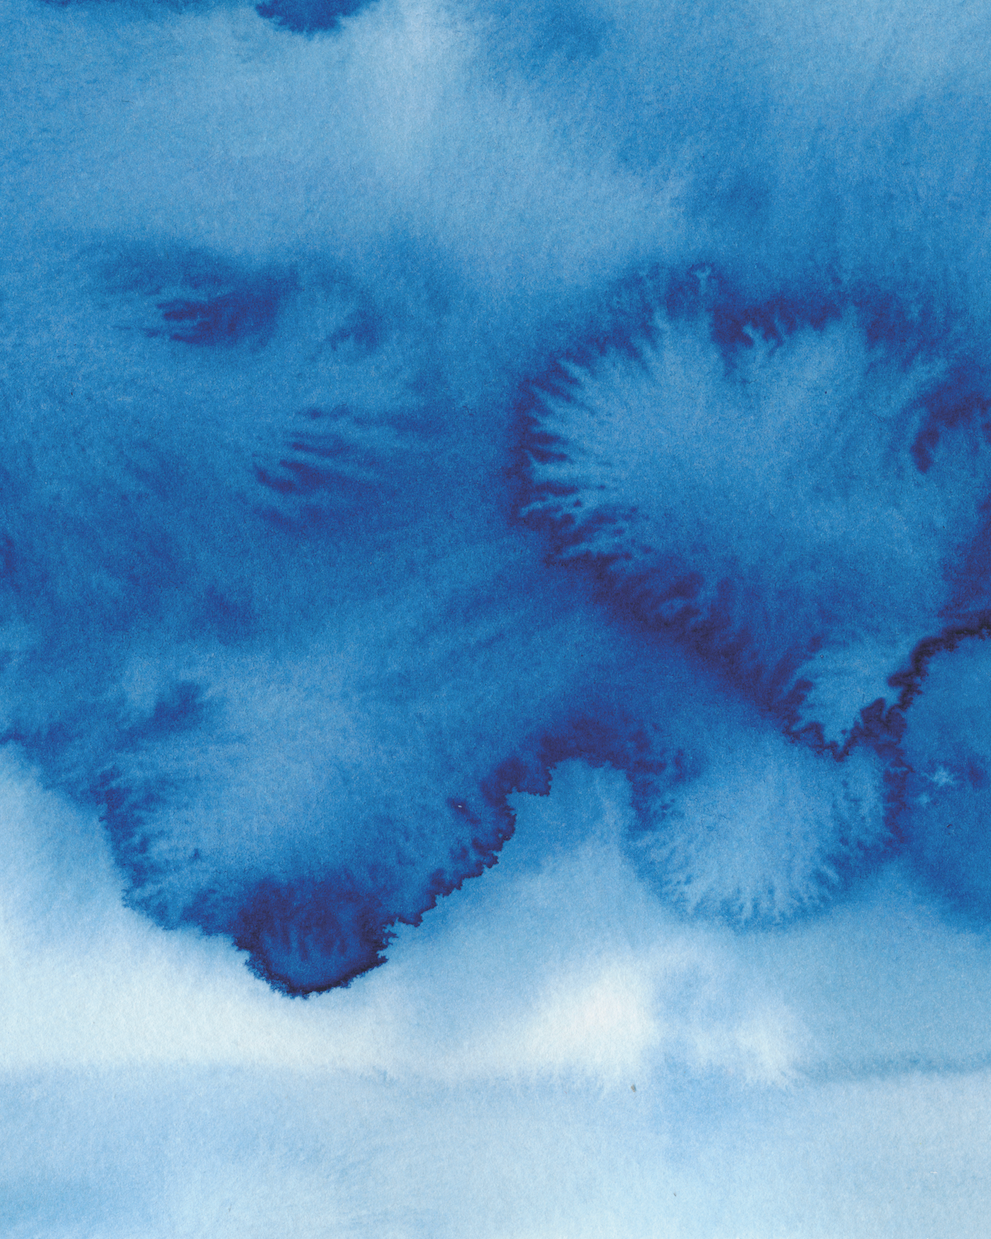

Design & creative strategy for brands on the rise.

Somers Creative provides ongoing design, video, and campaign support for brands that want to grow with clarity and confidence.
I help ambitious businesses and individuals build brands and develop creative solutions with clarity, confidence and momentum — blending thoughtful design, strategic marketing insight and scroll-stopping content craft.
Whether you need monthly design support, motion content, or full campaign direction, Somers Creative brings agency-level creativity with a flexible, collaborative approach. Helping SMEs, startups, and marketing teams turn strategy into standout visual communication.
Branding | Motion & Video | Design Support | Creative Direction
“Founded by creative director Lo Somers, Somers Creative bridges the gap between strategic thinking and expressive design.”
I work with ambitious businesses that need a creative partner - not just a supplier - to shape their visual identity and campaigns over time.
My approach blends agency experience with independent agility. Every project starts with insight: understanding your audience, your message, and your goals — then crafting design and content that move your brand forward.
I partner with growing businesses, founders and independent business owners who want agency-level thinking and execution - without the complexity or cookie-cutter approach.
Rooted in design. Built on strategy. Delivered with warmth, curiosity and care. From brand identities and social content to large scale multi-channel campaigns, I listen to where you want to be and help you get there.

Let’s Build Something Brilliant.
What I do
-

Branding & Visual Identity
Strategic brand foundations and standout visual systems that grow with your business.
• Brand strategy & messaging foundations
• Visual identity design & guidelines
• Brand systems and content toolkits
-

Motion & Video Content
Modern brands move — and your content should too.
• Short-form video & motion graphics
• Campaign assets & social ads
• Concept development & art direction
-

Design Support
Your on-demand creative partner - without agency overheads.
• Monthly creative support packages
• Design for digital, social & print
• Campaign creative & content production
-

Creative Direction & Campaign Strategy
From idea to delivery — clear direction, creative confidence.
• Campaign development & brand storytelling
• Multi-channel planning
• Founder/marketing team creative support
-

Event Stationery
For those who scrolled to find this service - yes, I still do stationery by request!
I offer bespoke and house collections in a range of styles for couples seeking beautiful personalised stationery.
Think you might want to work with me?
-
You need a friendly, reliable and experienced service. Ideally someone who can take your goals and ideas and help you translate them into well thought out design and strategy that gets real results.
You want a service that seamlessly blends creative craft with marketing strategy.
You need an accessible, flexible, collaborative creative - Trusted by global brands and ambitious independents.
-
14+ years in design, production, campaigns & brand building.
Skilled specialist in design, print production, video design, content creation and artistic direction.
Experience across charity, publishing & commercial sectors.
Multi-channel campaign experience (UK & international).
Trusted by global brands and ambitious independents.
East Yorkshire-based, working with clients across the UK and internationally.
Available for:
project work
brand partnerships
agency support
retainers
-
All you have to do is get in touch. Everything starts with an easy no-obligation conversation .
You can email me at lo@somers-creative.com or submit a contact form below.
